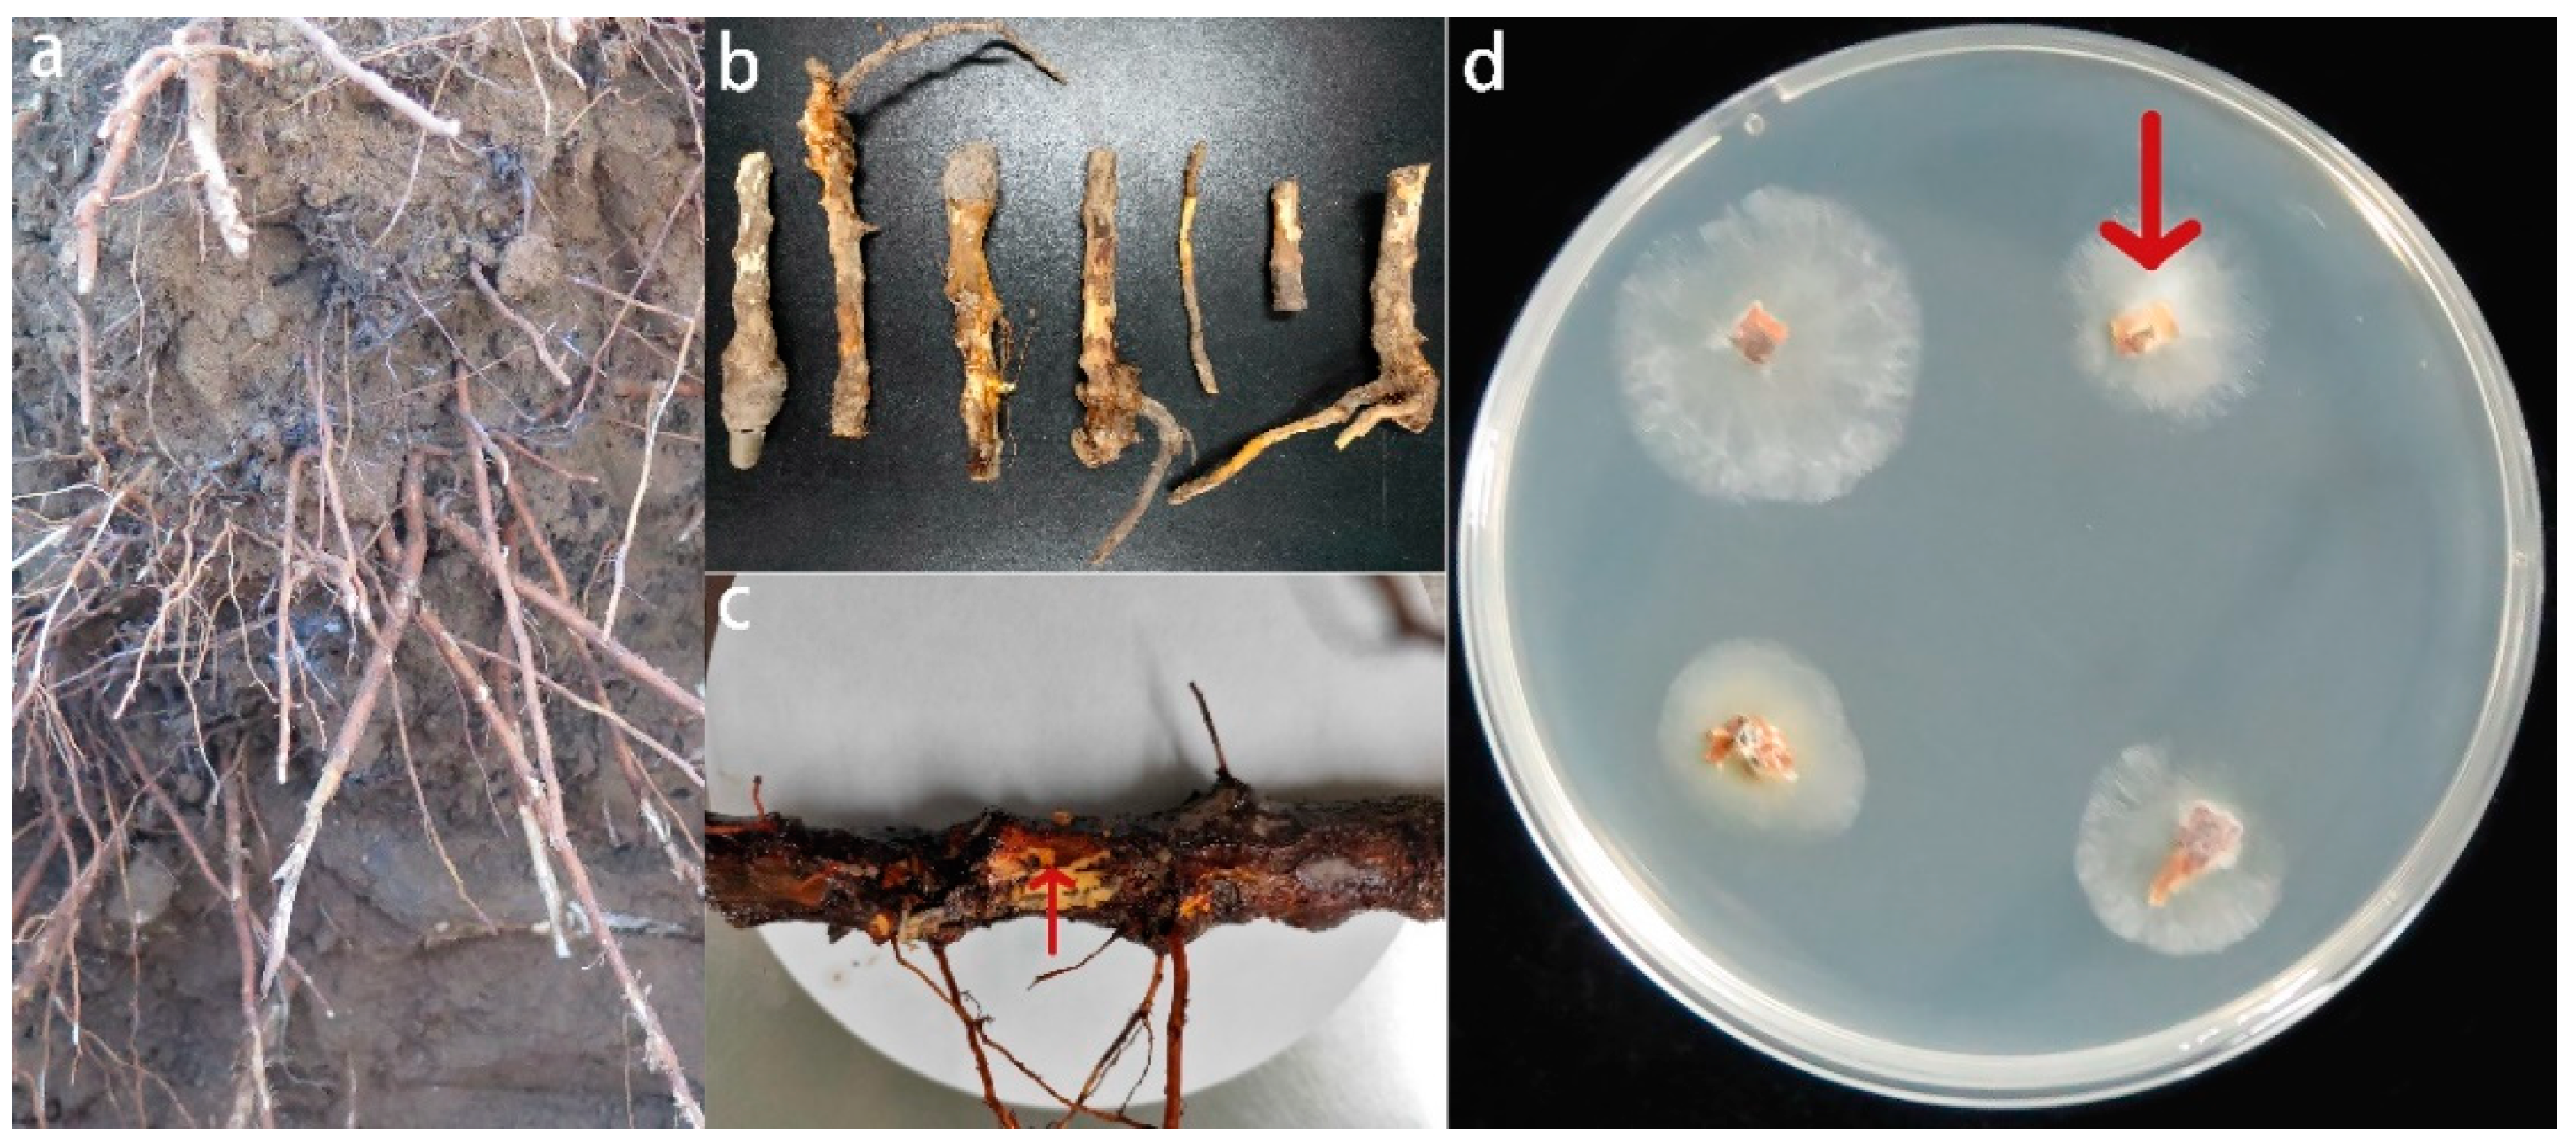
Jof 08 01071 g001 Jof 08 01071 g001
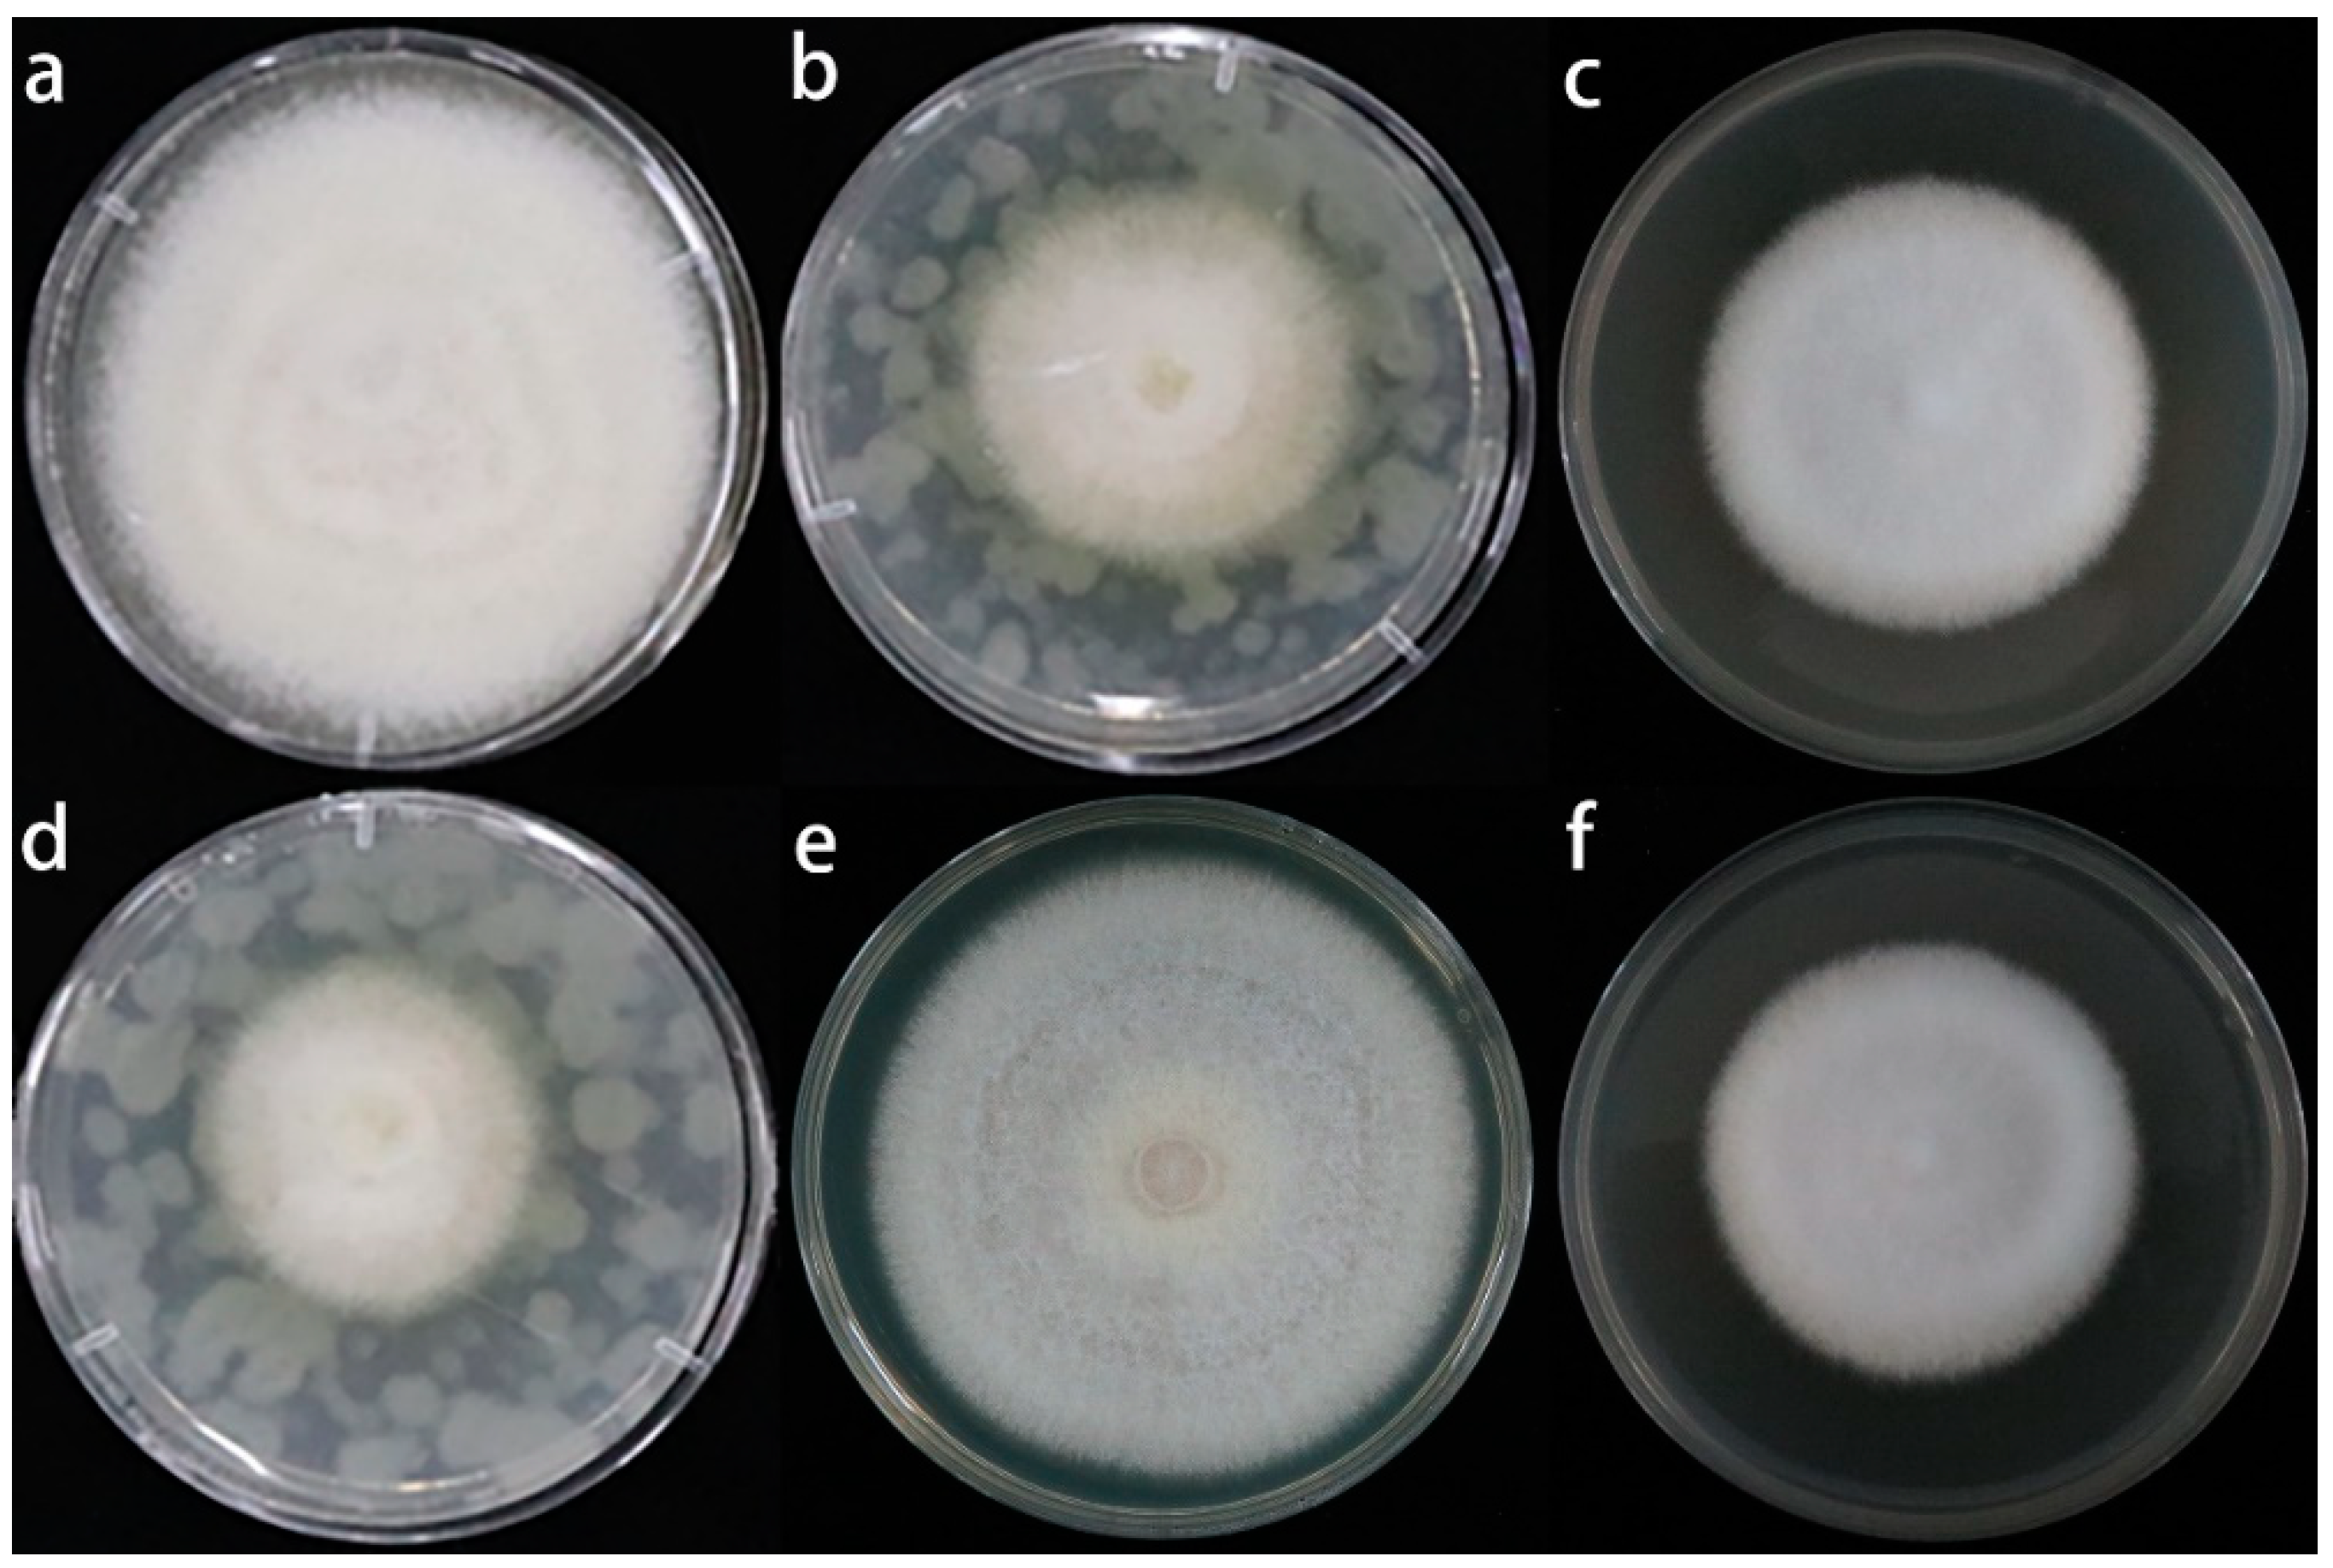
Jof 08 01071 g006 Jof 08 01071 g006

Allium fistulosum L. Alleviates Apple Replant Disease by Suppressing Fusarium solani
Abstract
1. Introduction
2. Materials and Methods
2.1. Fungal Pathogen Isolation and Identification
2.2. Pathogenicity Testing
2.3. Field Experiments
2.4. Design of Specific Primers and qPCR Specificity Analysis
2.5. Collection, Identification, and Quantification of the Root Exudates in A. fistulosum L. by GC-MS
2.6. Effects of the Root Exudates on the Mycelial Growth and Spore Germination of Fusarium solani Isolate HBH 08
2.7. Quantitative Real-Time PCR (qPCR) of Fusarium solani Isolate HBH 08 in Replanted Soil Treaded with Root Exudates
2.8. Statistical Analysis
3. Results
3.1. Isolation, Morphological Identification, and Pathogenicity Assays of the Fusarium solani Isolate HBH 08
3.2. Effect of Mixed Cropping of Grafted Apple Seedlings with A. fistulosum L. on the Biomass of Grafted Apple seedlings and Fusarium solani Isolate HBH 08
3.3. Quantification of Root Exudates and Their Effects on the Fusarium solani Isolate HBH 08
3.4. Effect of the Sulfur Compounds and Root Exudates of A. fistulosum L. on the Growth of M. hupenhensis Rehd. Seedlings and the Fusarium solani Isolate HBH 08 in Replanted Soil
4. Discussion
5. Conclusions
6. Patents
Supplementary Materials
Author Contributions
Funding
Institutional Review Board Statement
Informed Consent Statement
Data Availability Statement
Conflicts of Interest
References
- Mazzola, M. Elucidation of the microbial complex having a causal role in the development of apple replant disease in washington. Phytopathology 1998, 88, 930–938. [Google Scholar] [CrossRef]
- Jaffee, B.A.; Abawi, G.S.; Mai, W.F. Fungi Associated with Roots of Apple Seedlings Grown in Soil from an Apple Replant Site. Plant Dis. 1982, 66, 942. [Google Scholar] [CrossRef]
- Schoor, L.V.; Denman, S.; Cook, N.C. Characterisation of apple replant disease under South African conditions and potential biological management strategies. Sci. Hortic. 2009, 119, 153–162. [Google Scholar] [CrossRef]
- Mazzola, M. Transformation of soil microbial community structure and rhizoctonia-suppressive potential in response to apple roots. Phytopathology 1999, 89, 920–927. [Google Scholar] [CrossRef]
- Zhu, Y.; Fazio, G.; Mazzola, M. Elucidating the molecular responses of apple rootstock resistant to ARD pathogens: Challenges and opportunities for development of genomics-assisted breeding tools. Hort. Res. 2014, 1, 1404388. [Google Scholar] [CrossRef] [PubMed]
- Braun, P.G. Effects of Cylindrocarpon and Pythium species on apple seedlings and potential role in apple replant disease. Can. J. Plant Pathol. 2009, 17, 336–341. [Google Scholar] [CrossRef]
- Dullahide, S.R.; Stirling, G.R.; Nikulin, A.; Stirling, A.M. The role of nematodes, fungi, bacteria, and abiotic factors in the etiology of apple replant problems in the Granite Belt of Queensland. Aust. J. Exp. Agr. 1994, 34, 1177–1182. [Google Scholar] [CrossRef]
- Manici, L.M.; Ciavatta, C.; Kelderer, M.; Erschbaumer, G. Replant problems in South Tyrol: Role of fungal pathogens and microbial population in conventional and organic apple orchards. Plant Soil. 2003, 256, 315–324. [Google Scholar] [CrossRef]
- Sun, J.; Zhang, Q.; Li, X.L.; Zhou, B.B.; Wei, Q.P. Apple Replant Disorder of Pingyitiancha Rootstock is Closely Associated with Rhizosphere Fungal Community Development. J. Phytopathol. 2017, 165, 162–173. [Google Scholar] [CrossRef]
- Utkhede, R.S.; Vrain, T.C.; Yorston, J.M. Effects of nematodes, fungi and bacteria on the growth of young apple trees grown in apple replant disease soil. Plant Soil. 1992, 139, 1–6. [Google Scholar] [CrossRef]
- Xiang, L.; Zhao, L.; Wang, M.; Huang, J.X.; Chen, X.S.; Yin, C.M.; Mao, Z.Q. Physiological Responses of Apple Rootstock, M.9 to Infection by Fusarium solani. HortScience 2021, 56, 1104–1111. [Google Scholar] [CrossRef]
- Franke-Whittle, I.H.; Manici, L.M.; Insam, H.; Stres, B. Rhizosphere bacteria and fungi associated with plant growth in soils of three replanted apple orchards. Plant Soil. 2015, 395, 317–333. [Google Scholar] [CrossRef]
- Tewoldemedhin, Y.T.; Mazzola, M.; Labuschagne, I.; Mcleod, A. A multi-phasic approach reveals that apple replant disease is caused by multiple biological agents, with some agents acting synergistically. Soil Biol. Biochem. 2011, 43, 1917–1927. [Google Scholar] [CrossRef]
- Kelderer, M.; Manici, L.M.; Caputo, F.; Thalheimer, M. Planting in the ‘inter-row’ to overcome replant disease in apple orchards: A study on the effectiveness of the practice based on microbial indicators. Plant Soil. 2012, 357, 381–393. [Google Scholar] [CrossRef]
- Xiang, L.; Wang, M.; Jiang, W.T.; Wang, Y.F.; Chen, X.S.; Yin, C.M.; Mao, Z.Q. Key indicators for renewal and reconstruction of perennial trees soil: Microorganisms and phloridzin. Ecotoxicol. Environ. Saf. 2021, 225, 112723. [Google Scholar] [CrossRef]
- Xu, W.F. Diversity Analysis of Soil Fungi from Bohai Bay Apple Replanted Orchard and the Screening of the Antagoistic Fungi. Master’s Dissertation, Shandong Agricultural University, Tai’an, China, 2011. [Google Scholar]
- Liu, Z. Isolation and Identification of Fungi Pathogen from Apple Replant Disease in Bohai Bay region and the Screening of the Antagonistic Trichoderma strains. Master’s Dissertation, Shandong Agricultural University, Tai’an, China, 2013. [Google Scholar]
- Hadi, M.; Kashefi, B. Importance of mycotoxins and rapid detection of contamination in hazelnuts. Acta Hortic. 2012, 47–50. [Google Scholar] [CrossRef]
- Min, H.; Cho, B.K. Spectroscopic Techniques for Nondestructive Detection of Fungi and Myco-toxins in Agricultural Materials: A Review. J. Biosyst. Eng. 2015, 40, 67–77. [Google Scholar] [CrossRef]
- Rodica, S.; Olga, L. Quantification of ochratoxin A in moldavian wines. Sci. Study Res. Chem. Chem. Eng. Biotechnol. Food Ind. 2017, 18, 339–344. [Google Scholar]
- Lamprecht, S.C.; Tewoldemedhin, Y.T.; Botha, W.J.; Calitz, F.J. Fusarium graminearum Species Complex Associated with Maize Crowns and Roots in the KwaZulu-Natal Province of South Africa. Plant Dis. 2011, 95, 1153–1158. [Google Scholar] [CrossRef] [PubMed]
- Paudel, B.R.; Carpenter-Boggs, L.; Higgins, S. Influence of brassicaceous soil amendments on potentially beneficial and pathogenic soil microorganisms and seedling growth in Douglas-fir nurseries. Appl. Soil Ecol. 2016, 105, 91–100. [Google Scholar] [CrossRef]
- Tulin, A. Introductory Chapter: Fusarium: Pathogenicity, Infections, Diseases, Mycotoxins and Management. In Fusarium-Plant Diseases, Pathogen Diversity, Genetic Diversity, Resistance and Molecular Markers; Tulin, A., Ed.; IntechOpen: London, UK, 2018. [Google Scholar] [CrossRef]
- Yin, C.M.; Wang, M.; Wang, J.Y.; Chen, X.S.; Shen, X.; Zhang, M.; Mao, Z.Q. The Research Advance on Apple Replant Disease. Yuan Yi Xue Bao 2017, 44, 2215–2230. [Google Scholar] [CrossRef]
- Mazzola, M.; Strauss, S.L. Resilience of orchard replant soils to pathogen re-infestation in response to Brassicaceae seed meal amendment. Asp. Appl. Biol. 2013, 119, 69–77. [Google Scholar]
- Wang, Y.F.; Ma, Z.T.; Wang, X.W.; Sun, Q.R.; Dong, H.Q.; Wang, G.S.; Chen, X.S.; Yin, C.M.; Han, Z.H.; Mao, Z.Q. Effects of biochar on the growth of apple seedlings, soil enzyme activities and fungal communities in replant disease soil. Sci. Hortic-Amsterdam. 2019, 256, 108641. [Google Scholar] [CrossRef]
- Rogovska, N.; Laird, D.; Leandro, L.; Aller, D. Biochar effect on severity of soybean root disease caused by Fusarium virguliforme. Plant Soil. 2017, 413, 111–126. [Google Scholar] [CrossRef]
- Ascencion, L.C.; Liang, W.J.; Yen, T.B. Control of Rhizoctonia solani damping-off disease after soil amendment with dry tissues of Brassica results from increase in Actinomycetes population: Theory and applications in pest management. Biol. Control. 2015, 82, 21–30. [Google Scholar] [CrossRef]
- Javed, N.; Gowen, S.R.; El-Hassan, S.A.; Inam-Ul-Haq, M.; Shahina, F.; Pembroke, B. Efficacy of neem (Azadirachta indica) formulations on biology of root-knot nematodes (Meloidogyne javanica) on tomato. Crop Prot. 2007, 27, 36–43. [Google Scholar] [CrossRef]
- Natarajan, N.; Cork, A.; Boomathi, N.; Pandi, R.; Velavan, S.; Dhakshnamoorthy, G. Cold aqueous extracts of African marigold, Tagetes erecta for control tomato root knot nematode, Meloidogyne incognita. Crop Prot. 2006, 25, 1210–1213. [Google Scholar] [CrossRef]
- Caboni, P.; Saba, M.; Tocco, G.; Casu, L.; Murgia, A.; Maxia, A.; Menkissoglu-Spiroudi, U.; Ntalli, N. Nematicidal Activity of Mint Aqueous Extracts against the Root-Knot Nematode Meloidogyne incognita. J. Agr. Food Chem. 2013, 61, 9784–9788. [Google Scholar] [CrossRef]
- Cohen, M.F.; Yamasaki, H.; Mazzola, M. Brassica napus seed meal soil amendment modifies microbial community structure, nitric oxide production and incidence of Rhizoctonia root rot. Soil Biol. Biochem. 2004, 37, 1215–1227. [Google Scholar] [CrossRef]
- Sipes, B.S.; Arakaki, A.S. Root-knot Nematode Management in Dryland Taro with Tropical Cover Crops. J. Nematol. 1997, 29, 721–724. [Google Scholar] [CrossRef] [PubMed]
- Arnault, I.; Fleurance, C.; Vey, F.; Fretay, G.D.; Auger, J. Use of Alliaceae residues to control soil-borne pathogens. Ind. Crop. Prod. 2013, 49, 265–272. [Google Scholar] [CrossRef]
- Wang, H.Y.; Zhao, L.; Jiang, W.T.; Zhang, R.; Chen, R.; Mao, Y.F.; Chen, X.S.; Shen, X.; Yin, C.M.; Mao, Z.Q. Effects of Allium fistulosum-Brassica juncea-Triticum aestivum rotation a year on the soil microbial environment and the subsequent growth of young apple trees. Sci. Hortic. Amsterdam. 2021, 290, 110549. [Google Scholar] [CrossRef]
- Arnault, I.; Huchette, O.; Auger, J. Characterisation of aroma “type” in Allium species according to their S-alk(en)yl cysteine sulfoxides and γ-glutamyl dipeptides contents. Acta Hortic. 2010, 853, 171–182. [Google Scholar] [CrossRef]
- Deberdt, P.; Perrin, B.; Coranson-Beaudu, R.; Duyck, P.F.; Wicker, E. Effect of Allium fistulosum extract on Ralstonia solanacearum populations and tomato bacterial wilt. Plant Dis. 2012, 96, 687–692. [Google Scholar] [CrossRef]
- Mallek, S.B.; Prather, T.S.; Stapleton, J.J. Interaction effects of Allium spp. residues, concentrations and soil temperature on seed germination of four weedy plant species. Appl. Soil Ecol. 2007, 37, 233–239. [Google Scholar] [CrossRef]
- Wang, H.Y.; Zhang, R.; Duan, Y.N.; Jiang, W.T.; Chen, X.S.; Shen, X.; Yin, C.M.; Mao, Z.Q. The Endophytic Strain Trichoderma asperellum 6S-2: An Efficient Biocontrol Agent against Apple Replant Disease in China and a Potential Plant-Growth-Promoting Fungus. JoF 2021, 7, 1050. [Google Scholar] [CrossRef]
- Leslie, J.F.; Summerell, B.A. The Fusarium Laboratory Manual; Blackwell Publishing: Oxford, UK, 2006. [Google Scholar] [CrossRef]
- Arif, M.; Chawla, S.; Zaidi, N.W.; Rayar, J.K.; Variar, M.; Singh, U.S. Development of specific primers for genus Fusarium and F. solani using rDNA sub-unit and transcription elongation factor (TEF-1α) gene. Afr. J. Biotechnol. 2011, 11, 444–447. [Google Scholar] [CrossRef]
- O’Donnell, K.; Sarver, B.A.J.; Brandt, M.; Chang, D.C.; Noble-Wang, J.; Park, B.J.; Sutton, D.A.; Benjamin, L.; Lindsley, M.; Padhye, A.; et al. Phylogenetic Diversity and Microsphere Array-Based Genotyping of Human Pathogenic Fusaria, Including Isolates from the Multistate Contact Lens-Associated, U.S. Keratitis Outbreaks of 2005 and 2006. J. Clin. Microbiol. 2007, 45, 2235–2248. [Google Scholar] [CrossRef]
- Steinkellner, S.; Mammerler, R.; Vierheilig, H. Microconidia germination of the tomato pathogen Fusarium oxysporum in the presence of root exudates. J. Plant Interact. 2005, 1, 23–30. [Google Scholar] [CrossRef]
- Sun, S.L.; Zhu, L.; Sun, F.F.; Duan, C.X.; Zhu, Z.D. Pathotype diversity of Fusarium oxysporum f. sp. mungcola causing wilt on mungbean (Vigna radiata). Crop Pasture Sci. 2020, 71, 873–883. [Google Scholar] [CrossRef]
- Purwati, R.D.; Hidayah, N.; Sudjindro; Sudarsono. Inoculation Methods and Conidial Densities of Fusarium oxysporum f.sp. cubense in Abaca. HAYATI J. Biosci. 2008, 15, 1–7. [Google Scholar] [CrossRef]
- Chai, M.; Ho, Y.W.; Liew, K.W.; Asif, J.M. Biotechnology and in vitro mutagenesis for banana improvement. In Banana Improvement: Cellular, Molecular Biology, and Induced Mutations, Proceedings of a Meeting Held in Leuven, Belgium, 24–28 September 2001; Science Publishers: Beijing, China, 2004; pp. 51–68. [Google Scholar]
- Cachinero, J.M.; Hervás, A.; Jiménez-Díaz, R.; Tena, M. Plant defence reactions against fusarium wilt in chickpea induced by incompatible race 0 of Fusarium oxysporum f.sp. ciceris and nonhost isolates of F. oxysporum. Plant Pathol. 2002, 51, 765–776. [Google Scholar] [CrossRef]
- Xie, L.J. Study on the Antifungal mechanism of Glabridinagainst Fusarium graminearum. Master’s Dissertation, Sichuan Agricultural University, Ya’an, China, 2020. [Google Scholar] [CrossRef]
- Tewoldemedhin, Y.T.; Mazzola, M.; Botha, W.J.; Spies, C.F.J.; Mcleod, A. Characterization of fungi (Fusarium and Rhizoctonia) and oomycetes (Phytophthora and Pythium) associated with apple orchards in South Africa. Eur. J. Plant Pathol. 2011, 130, 215–229. [Google Scholar] [CrossRef]
- Sheng, Y.F.; Wang, H.Y.; Wang, M.; Li, H.H.; Xiang, L.; Pan, F.B.; Chen, X.S.; Shen, X.; Yin, C.M.; Mao, Z.Q. Effects of Soil Texture on the Growth of Young Apple Trees and Soil Microbial Community Structure Under Replanted Conditions. Hortic. Plant J. 2020, 6, 123–131. [Google Scholar] [CrossRef]
- Jevti, R.; Stoi, N.; Upunski, V.; Laloevi, M.; Orbovi, B. Variability of stem-base infestation and coexistence of Fusarium spp. causing crown rot of winter wheat in serbia. Plant Pathol. J. 2019, 35, 553–563. [Google Scholar] [CrossRef]
- Viswanathan, R. Fusarium diseases affecting sugarcane production in India. Indian Phytopathol. 2020, 73, 415–424. [Google Scholar] [CrossRef]
- Liu, K.J.; Luo, S.B.; Wang, Y.Q.; He, X.M.; Xie, D.S.; Peng, Q.W. Effects of Fusarium toxins on plant morphology and structure. Chin. Agric. Sci. Bull. 2010, 26, 53–56. [Google Scholar]
- Peng, J.; Wu, X.P.; Huang, H.Q.; Bao, S.X. Advances in Fusarium toxin research. Chin. Agric. Sci. Bull. 2009, 25, 3. [Google Scholar]
- Coleman, J.J. The Fusarium solani species complex: Ubiquitous pathogens of agricultural importance. Mol. Plant Pathol. 2016, 17, 146–158. [Google Scholar] [CrossRef]
- Toghueo, R.M.K.; Eke, P.; Zabalgogeazcoa, I.; Aldana, B.R.V.D.; González, Í.Z.; Nana, L.W.; Boyom, F.F. Biocontrol and growth enhancement potential of two endophytic Trichoderma spp. from Terminalia catappa against the causative agent of Common Bean Root Rot (Fusarium solani). Biol. Control 2016, 96, 8–20. [Google Scholar] [CrossRef]
- Sasan, R.K.; Bidochka, M.J. Antagonism of the endophytic insect pathogenic fungus Metarhizium robertsii against the bean plant pathogen Fusarium solani f. sp. phaseoli. Can. J. Plant Pathol. 2013, 35, 288–293. [Google Scholar] [CrossRef]
- Harman, G.L.; Huang, Y.H.; Nelson, R.L.; Noel, G.R. Germplasm Evaluation of Glycine max for Resistance to Fusarium solani, the Causal Organism of Sudden Death Syndrome. Plant Dis. 1997, 81, 515–518. [Google Scholar] [CrossRef] [PubMed]
- Wang, R.Y.; Gao, B.; Li, X.H.; Ma, J.; Chen, S.L. First Report of Fusarium solani Causing Fusarium Root Rot and Stem Canker on Storage Roots of Sweet Potato in China. Plant Dis. 2014, 98, 160–161. [Google Scholar] [CrossRef]
- Zou, Q.J.; Wang, S.T.; Liang, K.J.; Wang, Y.N.; Tong-Le, H.U.; Han, Z.Q.; Cao, K.Q. Suspected pathogenic Fusarium spp. isolated from apple orchard soils in Hebei Province. Mycosystema 2014, 33, 976–983. [Google Scholar] [CrossRef]
- Zhao, Y.; Wu, L.; Chu, L.; Yang, Y.; Li, Z.; Azeem, S.; Zhang, Z.; Fang, C.; Lin, W. Interaction of Pseudostellaria heterophylla with Fusarium oxysporum f.sp. heterophylla mediated by its root exudates in a consecutive monoculture system. Sci. Rep. 2015, 5, 8197. [Google Scholar] [CrossRef]
- Cotxarrera, L.; Trillas-Gay, M.I.; Steinberg, C.; Alabouvette, C. Use of sewage sludge compost and Trichoderma asperellum isolates to suppress Fusarium wilt of tomato. Soil Biol. Biochem. 2002, 34, 467–476. [Google Scholar] [CrossRef]
- Kowalchuk, G.A.; Os, G.J.V.; Aartrijk, J.V.; Veen, J.A.V. Microbial community responses to disease management soil treatments used in flower bulb cultivation. Biol. Fert. Soils 2003, 37, 198. [Google Scholar] [CrossRef]
- Zhang, H.; Mallik, A.; Zeng, R.S. Control of Panama Disease of Banana by Rotating and Intercropping with Chinese Chive (Allium Tuberosum Rottler): Role of Plant Volatiles. J. Chem. Ecol. 2013, 39, 243–252. [Google Scholar] [CrossRef]
- Zuluaga, D.L.; Kloeke, A.E.E.V.O.; Verkerk, R.; Röling, W.F.M.; Ellers, J.; Roelofs, D.; Aarts, M.G.M. Biofumigation using a wild Brassica oleracea accession with high glucosinolate content affects beneficial soil invertebrates. Plant Soil. 2015, 394, 155–163. [Google Scholar] [CrossRef][Green Version]
- Mazzola, M.; Zhao, X. Brassica juncea seed meal particle size influences chemistry but not soil biology-based suppression of individual agents inciting apple replant disease. Plant Soil. 2010, 337, 313–324. [Google Scholar] [CrossRef]
- Phaiphan, A.; Panichakool, P.; Jinawan, S.; Penjumras, P. Effects of heat and shallot (Allium ascalonicum L.) supplementation on nutritional quality and enzymatic browning of apple juice. J. Food Sci. Technol. 2019, 56, 4121–4128. [Google Scholar] [CrossRef] [PubMed]
- Li, J.J.; Xiang, L.; Pan, F.B.; Chen, X.S.; Shen, X.; Yin, C.M.; Mao, Z.Q. Effects of Malus hupehensis Seedlings and Allium fistulosum Mixed Cropping on Replanted Soil Environment. Yuan Yi Xue Bao. 2016, 43, 1853–1862. [Google Scholar] [CrossRef]
- Ahuja, I.; Rohloff, J.; Bones, A.M. Defence mechanisms of Brassicaceae: Implications for plant-insect interactions and potential for integrated pest management. A review. Agron. Sustain. Dev. 2010, 30, 311–348. [Google Scholar] [CrossRef]
- Mazzola, M.; Reardon, C.L.; Brown, J. Initial Pythium species composition and Brassicaceae seed meal type influence extent of Pythium-induced plant growth suppression in soil. Soil Biol. Biochem. 2012, 48, 20–27. [Google Scholar] [CrossRef]
- Croteau, G.A.; Zibilske, L.M. Influence of papermill processing residuals on saprophytic growth and disease caused by Rhi-zoctonia solani. Appl. Soil Ecol. 1998, 10, 103–115. [Google Scholar] [CrossRef]
- Manici, L.M.; Caputo, F.; Babini, V. Effect of green manure on Pythium spp. population and microbial communities in intensive cropping systems. Plant Soil. 2004, 263, 133–142. [Google Scholar] [CrossRef]
- Yulianti, T.; Sivasithamparam, K.; Turner, D.W. Saprophytic growth of Rhizoctonia solani Kühn AG2-1 (ZG5) in soil amended with fresh green manures affects the severity of damping-off in canola. Soil Biol. Biochem. 2006, 38, 923–930. [Google Scholar] [CrossRef]
- Yulianti, T.; Sivasithamparam, K.; Turner, D.W. Saprophytic and pathogenic behaviour of R. solani AG2-1 (ZG-5) in a soil amended with Diplotaxis tenuifolia or Brassica nigra manures and incubated at different temperatures and soil water content. Plant Soil. 2007, 294, 277–289. [Google Scholar] [CrossRef]
- Arslan, U. Evaluation of Antifungal Activity of Sulfur-Containing Salts against Phytopathogenic Fungi. Fresen. Environ. Bull. 2015, 24, 1879–1886. [Google Scholar]
- Bai, Y.B.; Gao, Y.Q.; Nie, X.D.; Tuong, T.M.L.; Li, D.; Gao, J.M. Antifungal Activity of Griseofulvin Derivatives against Phytopathogenic Fungi in Vitro and in Vivo and Three-Dimensional Quantitative Structure-Activity Relationship Analysis. J. Agr. Food Chem. 2019, 67, 6125–6132. [Google Scholar] [CrossRef]

| Locus | Gene Product | Primer | Sequence (5′-3′) |
|---|---|---|---|
| ITS | Internal transcribed spacer | ITS1 | TCCGTAGGTGAACCTGCGG |
| ITS4 | TCCTCCGCTTATTGATAGC | ||
| TEF1α | Translation elongation factor 1-alpha | TEF-Fs4f | ATCGGCCACGTCGACTCT |
| TEF-Fs4r | GGCGTCTGTTGATTGTTAGC | ||
| RPB2 | RNA polymerase II second largest subunit | RPB2-5F2 | GGGGWGAYCAGAAGAAGGC |
| RPB2-7cR | CCCATRGCTTGYTTRCCCAT |
| Sampling Time | Treatment | Plant Height (cm) | Fresh Weight (kg) |
|---|---|---|---|
| The first year | MB | 196 ± 3.46 a | 5.10 ± 0.11 a |
| MC | 180.67 ± 4.91 b | 4.07 ± 0.23 b | |
| UN | 154.33 ± 2.97 c | 2.39 ± 0.13 c | |
| The second year | MB | 256.67 ± 7.45 a | 8.50 ± 0.32 a |
| MC | 247.33 ± 5.90 a | 6.57 ± 0.34 b | |
| UN | 209.00 ± 4.04 b | 3.59 ± 0.27 c |
| Compound | Relative Content % | Compound | Relative Content % |
|---|---|---|---|
| 2,6,10-Trimethyldodecane | 0.31 | Hexadecanoic acid, methyl ester | 0.51 |
| 2-Bromotetradecane | 0.31 | Dibutyl phthalate | 0.46 |
| 3-Ethyl-3-methylheptane | 0.11 | Acetic acid, n-octadecyl ester | 0.23 |
| Cyclononasiloxane, octadecamethyl- | 0.33 | Sulfurous acid, diisobutyl ester | 0.18 |
| Decane | 0.14 | Benzene, 1,2,4,5-tetramethyl | 0.34 |
| Decyl iodide | 0.27 | Benzene, pentamethyl- | 0.38 |
| Dodecane, 4,6-dimethyl- | 0.47 | Ethylbenzene | 3.25 |
| Dodecane | 0.46 | M-xylene | 8.02 |
| Eicosane | 0.32 | O-Xylene | 3.93 |
| Heptadecane, 8-methyl- | 0.21 | Benzyl alcohol | 0.64 |
| Hexadecane | 0.61 | Isotridecanol- | 0.36 |
| Hexane, 3,3-dimethyl- | 0.45 | Methanethiol | 1.84 |
| Nonane, 5-methyl-5-propyl- | 0.21 | Dithioglycol | 1.02 |
| Octane, 2,3,6,7-tetramethyl- | 0.26 | Naphthalene | 0.51 |
| Pentadecane, 4-methyl- | 0.19 | Naphthalene, 1-methyl- a- | 1.81 |
| Tetradecane, 4-methyl- | 0.33 | Naphthalene, 2,3-dimethyl- | 0.33 |
| Tetradecane | 0.71 | Naphthalene, 2,6-dimethyl- | 0.42 |
| Undecane, 4,8-dimethyl- | 0.28 | Phenol, 2,2’-methylenebis [6-(1,1-dimethylethyl)-4-methyl- | 0.2 |
| Nonadecane, 4-methyl- | 0.36 | Phenol, 2,6-bis(1,1-dimethylethyl)- | 0.16 |
| Dotriacontane | 0.74 | Phenol, 3-pentadecyl- 3- | 0.4 |
| 1,2-Benzenedicarboxylic acid, diisooctyl ester | 0.77 | Dimethyl disulphide | 1.04 |
| 1-Hexadecanol, acetate | 0.37 | Diallyl disulphide | 0.7 |
| Diethyl phthalate | 0.15 | Dibenzofuran | 0.29 |
| Diisooctyl phthalate | 2.26 | Fluorene | 0.39 |
| Heptadecanoic acid, 16-methyl-, methyl ester | 0.18 | Urea, N’-methyl-N, N-diphenyl- | 50.61 |
| Methyl 13-methyltetradecanoate | 0.57 | 2-Naphthalenamine, N-phenyl- N- | 0.98 |
| Octadecanoic acid, methyl ester | 0.42 | Methanesulfonylacetic | 0.86 |
| Phthalic acid, diisobutyl ester | 1.36 | Others | 6.99 |
| Treatment | Plant Height (cm) | Fresh Weight (g) |
|---|---|---|
| MB | 74.67 ± 3.28 a | 63.78 ± 4.08 a |
| DMDS | 48.33 ± 1.86 c | 36.75 ± 1.82 b,c |
| DADS | 46.00 ± 1.73 c | 31.29 ± 0.85 c |
| RE | 59.00 ± 2.31 b | 40.92 ± 3.82 b |
| UN | 35.67 ± 1.76 d | 21.88 ± 1.35 d |
Publisher’s Note: MDPI stays neutral with regard to jurisdictional claims in published maps and institutional affiliations. |
© 2022 by the authors. Licensee MDPI, Basel, Switzerland. This article is an open access article distributed under the terms and conditions of the Creative Commons Attribution (CC BY) license (https://creativecommons.org/licenses/by/4.0/).
Share and Cite
Tang, W.; Wang, G.; Chen, R.; Liu, X.; Chen, X.; Shen, X.; Yin, C.; Mao, Z. Allium fistulosum L. Alleviates Apple Replant Disease by Suppressing Fusarium solani. J. Fungi 2022, 8, 1071. https://doi.org/10.3390/jof8101071
Tang W, Wang G, Chen R, Liu X, Chen X, Shen X, Yin C, Mao Z. Allium fistulosum L. Alleviates Apple Replant Disease by Suppressing Fusarium solani. Journal of Fungi. 2022; 8(10):1071. https://doi.org/10.3390/jof8101071
Chicago/Turabian StyleTang, Weixiao, Gongshuai Wang, Ran Chen, Xin Liu, Xuesen Chen, Xiang Shen, Chengmiao Yin, and Zhiquan Mao. 2022. "Allium fistulosum L. Alleviates Apple Replant Disease by Suppressing Fusarium solani" Journal of Fungi 8, no. 10: 1071. https://doi.org/10.3390/jof8101071
APA StyleTang, W., Wang, G., Chen, R., Liu, X., Chen, X., Shen, X., Yin, C., & Mao, Z. (2022). Allium fistulosum L. Alleviates Apple Replant Disease by Suppressing Fusarium solani. Journal of Fungi, 8(10), 1071. https://doi.org/10.3390/jof8101071

